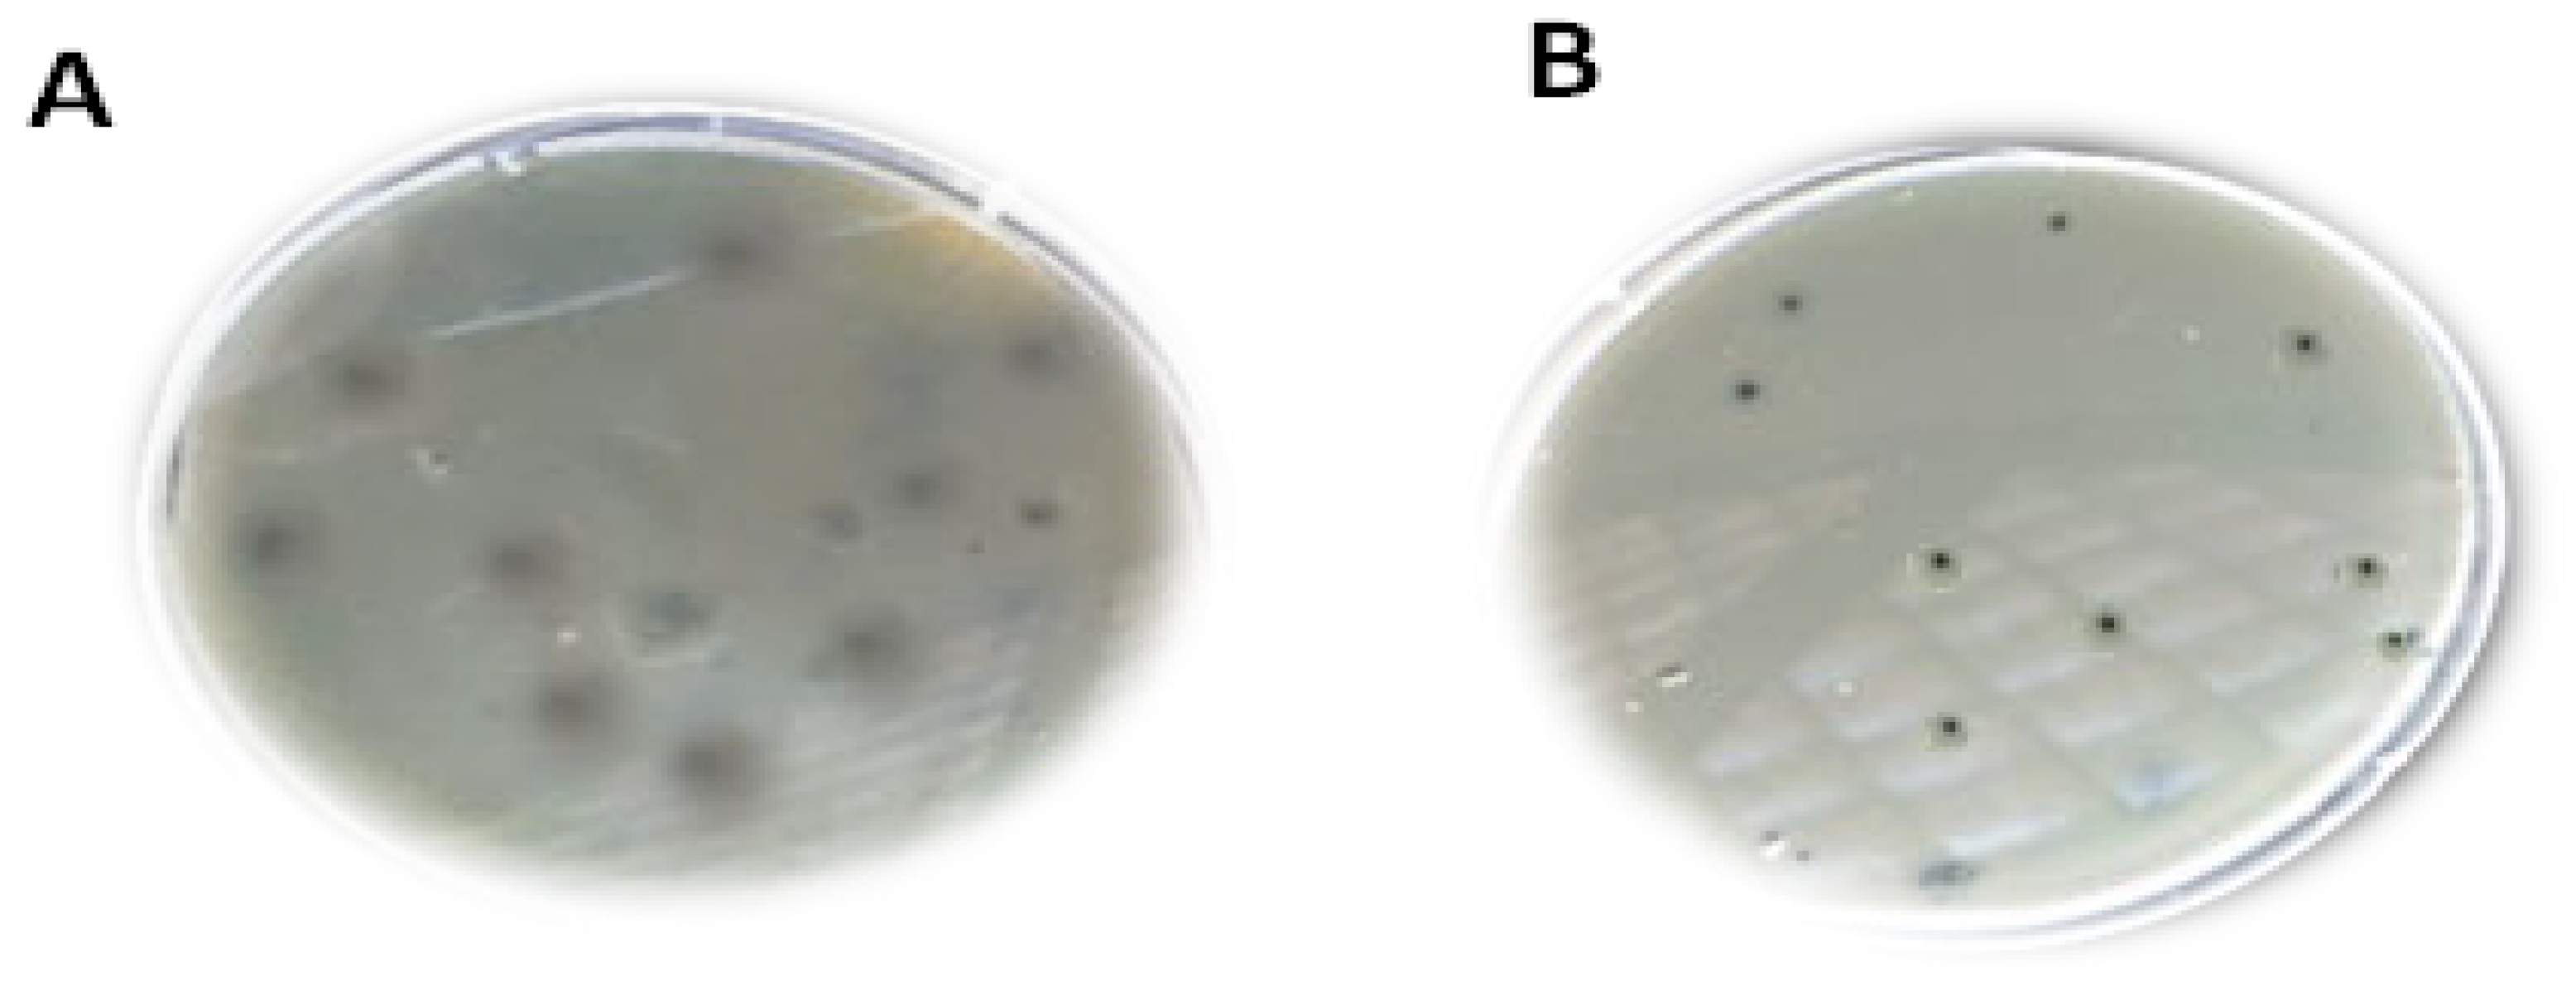
Medicina 60 00501 g003

Fully Characterized Effective Bacteriophages Specific against Antibiotic-Resistant Enterococcus faecalis, the Causative Agent of Dental Abscess
Abstract
1. Introduction
2. Materials and Methods
2.1. Chemicals Used
2.2. Isolation of Enterococci
2.3. Ethical Approval and Consent Form
2.4. Identification of Enterococcus spp.
2.5. Antibiotic Susceptibility Test
2.6. Bacterial Genomic Identification through 16S rRNA Sequencing
Purification and Analysis of the PCR Product
2.7. Bacteriophage Isolation
2.7.1. Purification of Phages
2.7.2. Characterization of E. faecalis Phage
Transmission Electron Microscopy (TEM)
2.7.3. Genomic Identification of Phages
PCR Conditions
Bioinformatics and In Silico Analysis of Enterococcus Phages
2.7.4. Phage Optimization
One-Step Growth Curve
Phage Host Range
Phage Thermal and pH Stability
Production of Concentrated Purified Phage
Determination of Phage Cytotoxicity on Cells (MTT Assay)
2.8. Statistical Analysis
3. Results
3.1. Isolation of Enterococci
3.2. Antibiotic Susceptibility
3.3. Genomic Identification of Bacterial Isolates
3.4. Phage Isolation and Characterization
3.5. Bioinformatics and In Silico Analysis of Enterococcus Phage
3.6. Host Range Activity
3.7. Genetic Identification of Bacteriophage
3.8. One-Step Growth Curve
3.9. Thermal and pH Stability
3.10. Cytotoxic Effect
4. Discussion
5. Conclusions
Supplementary Materials
Author Contributions
Funding
Institutional Review Board Statement
Informed Consent Statement
Data Availability Statement
Acknowledgments
Conflicts of Interest
References
- Stephens, M.B.; Wiedemer, J.P.; Kushner, G.M. Dental problems in primary care. Am. Fam. Physician 2018, 98, 654–660. [Google Scholar]
- Roberts, R.M.; Hersh, A.L.; Shapiro, D.J.; Fleming-Dutra, K.E.; Hicks, L.A.J. Antibiotic prescriptions associated with dental-related emergency department visits. Ann. Emerg. Med. 2019, 74, 45–49. [Google Scholar] [CrossRef]
- Hailu, F.A.; Hailu, Y.A.; Hailu, T.A. Dental anatomy and physiology of human tooth and the consequences of pathogenic microbiota on the oral cavity. J. Clin. Case Stud. Rev. Rep. 2020, 2, 1–7. [Google Scholar] [CrossRef]
- Shakya, M.; Kayastha, P.K.; Jiao, H. Oral flora: Protection or destruction of dental tissue. Int. J. Endorsing Health Sci. Res. (IJEHSR) 2018, 6, 47–57. [Google Scholar] [CrossRef]
- Schmidt, J.; Kunderova, M.; Pilbauerova, N.; Kapitan, M. A review of evidence-based recommendations for pericoronitis management and a systematic review of antibiotic prescribing for pericoronitis among dentists: Inappropriate pericoronitis treatment is a critical factor of antibiotic overuse in dentistry. Int. J. Environ. Res. Public Health 2021, 18, 6796. [Google Scholar] [CrossRef]
- Arhun, N.; Arman-Özçırpıcı, A.; Çehreli, S.B.; Gülşahı, K.; Özsoy, Ö.P. The Restorative Dentist and Orthodontist: Orthodontic Implications of Dental Caries, Tooth Fracture, Exposed Dental Pulp, and Esthetic Improvements. Integr. Clin. Orthod. 2023, 345–410. [Google Scholar]
- Thompson, W.; McEachan, R.; Pavitt, S.; Douglas, G.; Bowman, M.; Boards, J.; Sandoe, J. Clinician and patient factors influencing treatment decisions: Ethnographic study of antibiotic prescribing and operative procedures in out-of-hours and general dental practices. Antibiotics 2020, 9, 575. [Google Scholar] [CrossRef] [PubMed]
- Zaken, H.B.; Kraitman, R.; Coppenhagen-Glazer, S.; Khalifa, L.; Alkalay-Oren, S.; Ben-Gal, G.; Beyth, N.; Hazan, R. Isolation and characterization of anti-Streptococcus mutans phage as a possible treatment agent for caries. Viruses 2021, 13, 825. [Google Scholar] [CrossRef]
- Ayesha, F. Polymicrobial Interactions between Selected Microbes of Oral Biofilm and Differential Expression of ALS Genes and Their Related Proteins/Ayesha Fahim. Doctoral Dissertation, Universiti Malaya, Kuala Lumpur, Malaysia, 2020. [Google Scholar]
- Geraldes, C.; Tavares, L.; Gil, S.; Oliveira, M. Enterococcus Virulence and Resistant Traits Associated with Its Permanence in the Hospital Environment. Antibiotics 2022, 11, 857. [Google Scholar] [CrossRef] [PubMed]
- García-Solache, M.; Rice, L.B. The Enterococcus: A model of adaptability to its environment. Clin. Microbiol. Rev. 2019, 32. [Google Scholar] [CrossRef]
- Liu, C.; Hong, Q.; Chang, R.Y.K.; Kwok, P.C.L.; Chan, H.-K. Phage–Antibiotic therapy as a promising strategy to combat multidrug-resistant infections and to enhance antimicrobial efficiency. Antibiotics 2022, 11, 570. [Google Scholar] [CrossRef]
- Federici, S.; Nobs, S.P.; Elinav, E. Phages and their potential to modulate the microbiome and immunity. Cell. Mol. Immunol. 2021, 18, 889–904. [Google Scholar] [CrossRef]
- Marantos, A. Population Dynamics of Phage-Bacteria Ecosystems under Challenging Conditions. Ph.D. Thesis, School of The Faculty of Science, University of Copenhagen, København, Denmark, 2023. [Google Scholar]
- Liu, D.; Van Belleghem, J.D.; de Vries, C.R.; Burgener, E.; Chen, Q.; Manasherob, R.; Aronson, J.R.; Amanatullah, D.F.; Tamma, P.D.; Suh, G.A. The safety and toxicity of phage therapy: A review of animal and clinical studies. Viruses 2021, 13, 1268. [Google Scholar] [CrossRef]
- Ssekatawa, K.; Byarugaba, D.K.; Kato, C.D.; Wampande, E.M.; Ejobi, F.; Tweyongyere, R.; Nakavuma, J.L. A review of phage mediated antibacterial applications. Alex. J. Med. 2021, 57, 1–20. [Google Scholar] [CrossRef]
- Łobocka, M.; Dąbrowska, K.; Górski, A. Engineered bacteriophage therapeutics: Rationale, challenges and future. BioDrugs 2021, 35, 255–280. [Google Scholar] [CrossRef] [PubMed]
- Abdelsattar, A.; Dawoud, A.; Makky, S.; Nofal, R.; Aziz, R.K.; El-Shibiny, A. Bacteriophages: From isolation to application. Curr. Pharm. Biotechnol. 2022, 23, 337–360. [Google Scholar] [CrossRef] [PubMed]
- Chung, K.M.; Nang, S.C.; Tang, S. The Safety of Bacteriophages in Treatment of Diseases Caused by Multidrug-Resistant Bacteria. Pharmaceuticals 2023, 16, 1347. [Google Scholar] [CrossRef] [PubMed]
- Miller, J.M.; Miller, S.A. A Guide to Specimen Management in Clinical Microbiology; John Wiley & Sons: Hoboken, NJ, USA, 2017. [Google Scholar]
- Gupta, A.; Shah, A.A.; Khursheed, S.; Rashid, A.; Kumar, V. Isolation, identification, speciation, and antibiogram of enterococcus species by conventional methods and assessment of the prevalence of vana genotype among VRE. J. Med. Pharm. Allied. Sci. 2022, 11, 5037–5044. [Google Scholar] [CrossRef]
- Alhamadani, Y.S.T.; Oudah, A.S. Study of the Bacterial Sensitivity to different Antibiotics which are isolated from patients with UTI using Kirby-Bauer Method. J. Biomed. Biochem. 2022, 1. [Google Scholar] [CrossRef]
- Asbell, P.A.; Sanfilippo, C.M.; Sahm, D.F.; DeCory, H.H. Trends in antibiotic resistance among ocular microorganisms in the United States from 2009 to 2018. JAMA Ophthalmol. 2020, 138, 439–450. [Google Scholar] [CrossRef]
- Alsamman, A.M.; Khedr, M.; Kabary, H.A.; El-Sehrawy, M. Elimination of pathogenic multidrug resistant isolates through different metal oxide nanoparticles synthesized from organic plant and microbial sources. Microb. Pathog. 2023, 178, 106055. [Google Scholar] [CrossRef]
- Church, D.L.; Cerutti, L.; Gürtler, A.; Griener, T.; Zelazny, A.; Emler, S. Performance and application of 16S rRNA gene cycle sequencing for routine identification of bacteria in the clinical microbiology laboratory. Clin. Microbiol. Rev. 2020, 33. [Google Scholar] [CrossRef]
- Thung, T.; Siti Norshafawatie, B.; Premarathne, J.; Chang, W.; Loo, Y.; Kuan, C.; New, C.; Ubong, A.; Ramzi, O.; Mahyudin, N.A.; et al. Isolation of food-borne pathogen bacteriophages from retail food and environmental sewage. Int. Food Res. J. 2017, 24, 450. [Google Scholar]
- Kifelew, L.G.; Warner, M.S.; Morales, S.; Thomas, N.; Gordon, D.L.; Mitchell, J.G.; Speck, P.G. Efficacy of lytic phage cocktails on Staphylococcus aureus and Pseudomonas aeruginosa in mixed-species planktonic cultures and biofilms. Viruses 2020, 12, 559. [Google Scholar] [CrossRef]
- Nguyen, L.V. Evaluation of Variables Affecting the Success of Typing Shed Dog Hair Using Direct PCR; University of California: Davis, CA, USA, 2020. [Google Scholar]
- Andrade-Martínez, J.S.; Camelo Valera, L.C.; Chica Cardenas, L.A.; Forero-Junco, L.; López-Leal, G.; Moreno-Gallego, J.L.; Rangel-Pineros, G.; Reyes, A.J.M.; Reviews, M.B. Computational tools for the analysis of uncultivated phage genomes. Microbiol. Mol. Biol. Rev. 2022, 86, e00004-21. [Google Scholar] [CrossRef] [PubMed]
- Alcock, B.P.; Raphenya, A.R.; Lau, T.T.; Tsang, K.K.; Bouchard, M.; Edalatmand, A.; Huynh, W.; Nguyen, A.-L.V.; Cheng, A.A.; Liu, S.; et al. CARD 2020: Antibiotic resistome surveillance with the comprehensive antibiotic resistance database. Nucleic Acids Res. 2020, 48, D517–D525. [Google Scholar] [CrossRef] [PubMed]
- Kumar, S.; Stecher, G.; Li, M.; Knyaz, C.; Tamura, K. MEGA X: Molecular evolutionary genetics analysis across computing platforms. Mol. Biol. Evol. 2018, 35, 1547. [Google Scholar] [CrossRef] [PubMed]
- Kropinski, A.M.; Mazzocco, A.; Waddell, T.E.; Lingohr, E.; Johnson, R.P. Enumeration of bacteriophages by double agar overlay plaque assay. In Bacteriophages; Methods in Molecular Biology; Humana Press: New York, NY, USA, 2009; pp. 69–76. [Google Scholar]
- Wang, R.; Xing, S.; Zhao, F.; Li, P.; Mi, Z.; Shi, T.; Liu, H.; Tong, Y. Characterization and genome analysis of novel phage vB_EfaP_IME195 infecting Enterococcus faecalis. Virus Genes 2018, 54, 804–811. [Google Scholar] [CrossRef] [PubMed]
- Mekky, A.E.; Emam, A.E.; Selim, M.N.; Abdelmouty, E.S.; Khedr, M. Antibacterial and antineoplastic MCF-7 and HePG-2 characteristics of the methanolic (80%) clove (Syzygium aromaticum L.) extract. Biomass Convers. Biorefinery 2023, 1–12. [Google Scholar] [CrossRef]
- Najafi, K.; Ganbarov, K.; Gholizadeh, P.; Tanomand, A.; Rezaee, M.A.; Mahmood, S.S.; Asgharzadeh, M.; Kafil, H.S. Oral cavity infection by Enterococcus faecalis: Virulence factors and pathogenesis. Rev. Res. Med. Microbiol. 2020, 31, 51–60. [Google Scholar] [CrossRef]
- Wong, J.; Manoil, D.; Näsman, P.; Belibasakis, G.N.; Neelakantan, P. Microbiological aspects of root canal infections and disinfection strategies: An update review on the current knowledge and challenges. Front. Oral Health 2021, 2, 672887. [Google Scholar] [CrossRef] [PubMed]
- Hyman, P. Phages for phage therapy: Isolation, characterization, and host range breadth. Pharmaceuticals 2019, 12, 35. [Google Scholar] [CrossRef]
- Xing, S.; Zhang, X.; Sun, Q.; Wang, J.; Mi, Z.; Pei, G.; Huang, Y.; An, X.; Fu, K.; Zhou, L.; et al. Complete genome sequence of a novel, virulent Ahjdlikevirus bacteriophage that infects Enterococcus faecium. Arch. Virol. 2017, 162, 3843–3847. [Google Scholar] [CrossRef] [PubMed]
- Nasr-Eldin, M.A.; El-Dougdoug, N.K.; Elazab, Y.H.; Esmael, A. Isolation and Characterization of Two Virulent Phages to Combat Staphylococcus aureus and Enterococcus faecalis causing Dental Caries. J. Pure Appl. Microbiol. 2021, 15, 320–334. [Google Scholar] [CrossRef]
- Esmael, A.; Hassan, M.G.; Amer, M.M.; Abdelrahman, S.; Hamed, A.M.; Abd-Raboh, H.A.; Foda, M.F. Antimicrobial activity of certain natural-based plant oils against the antibiotic-resistant acne bacteria. Saudi J. Biol. Sci. 2020, 27, 448–455. [Google Scholar] [CrossRef] [PubMed]
- Esmat, M.M.; Abdelhamid, A.G.; Abo-ELmaaty, S.A.; Nasr-Eldin, M.A.; Hassan, M.G.; Khattab, A.A.; Esmael, A. Antibiotics and phage sensitivity as interventions for controlling Escherichia coli isolated from clinical specimens. J. Pure Appl. Microbiol. 2017, 11, 1749–1755. [Google Scholar] [CrossRef]
- El-Telbany, M.; El-Didamony, G.; Askora, A.; Ariny, E.; Abdallah, D.; Connerton, I.F.; El-Shibiny, A. Bacteriophages to control multi-drug resistant Enterococcus faecalis infection of dental root canals. Microorganisms 2021, 9, 517. [Google Scholar] [CrossRef]
- Xiang, Y.; Ma, C.; Yin, S.; Song, F.; Qin, K.; Ding, Y.; Yang, X.; Song, P.; Ji, X.; Wei, Y. Phage therapy for refractory periapical periodontitis caused by Enterococcus faecalis in vitro and in vivo. Appl. Microbiol. Biotechnol. 2022, 106, 2121–2131. [Google Scholar] [CrossRef]
- Bhardwaj, S.B.; Mehta, M.; Sood, S.; Sharma, J. Isolation of a novel phage and targeting biofilms of drug-resistant oral enterococci. J. Glob. Infect. Dis. 2020, 12, 11. [Google Scholar] [CrossRef]
- Dion, M.B.; Oechslin, F.; Moineau, S. Phage diversity, genomics and phylogeny. Nat. Rev. Microbiol. 2020, 18, 125–138. [Google Scholar] [CrossRef]
- Pires, D.P.; Costa, A.R.; Pinto, G.; Meneses, L.; Azeredo, J. Current challenges and future opportunities of phage therapy. FEMS Microbiol. Rev. 2020, 44, 684–700. [Google Scholar] [CrossRef]
- McGee, L.W.; Barhoush, Y.; Shima, R.; Hennessy, M. Phage-resistant mutations impact bacteria susceptibility to future phage infections and antibiotic response. Ecol. Evol. 2023, 13, e9712. [Google Scholar] [CrossRef]
- Canfield, G.S.; Chatterjee, A.; Espinosa, J.; Mangalea, M.R.; Sheriff, E.K.; Keidan, M.; McBride, S.W.; McCollister, B.D.; Hang, H.C.; Duerkop, B.A. Lytic bacteriophages facilitate antibiotic sensitization of Enterococcus faecium. Antimicrob. Agents Chemother. 2021, 65. [Google Scholar] [CrossRef]
- Liu, J.; Zhu, Y.; Li, Y.; Lu, Y.; Xiong, K.; Zhong, Q.; Wang, J. Bacteriophage-Resistant Mutant of Enterococcus faecalis Is Impaired in Biofilm Formation. Front. Microbiol. 2022, 13, 913023. [Google Scholar] [CrossRef]
- Li, X.; He, Y.; Wang, Z.; Wei, J.; Hu, T.; Si, J.; Tao, G.; Zhang, L.; Xie, L.; Abdalla, A.E.; et al. A combination therapy of Phages and Antibiotics: Two is better than one. Int. J. Biol. Sci. 2021, 17, 3573. [Google Scholar] [CrossRef]
- Morrisette, T.; Kebriaei, R.; Lev, K.L.; Morales, S.; Rybak, M.J. Bacteriophage therapeutics: A primer for clinicians on phage-antibiotic combinations. Pharmacother. J. Hum. Pharmacol. Drug Ther. 2020, 40, 153–168. [Google Scholar] [CrossRef] [PubMed]
- Lauman, P.; Dennis, J.J. Advances in phage therapy: Targeting the Burkholderia cepacia complex. Viruses 2021, 13, 1331. [Google Scholar] [CrossRef] [PubMed]
- Xue, J.; Mirzaei, M.K.; Costa, R.; Smith, S.; Tiamani, K.; Ma, T.; Deng, L. Human virome in health and disease. In Molecular Medical Microbiology; Elsevier: Amsterdam, The Netherlands, 2024; pp. 2641–2658. [Google Scholar]
- Abril, A.G.; Carrera, M.; Notario, V.; Sánchez-Pérez, Á.; Villa, T.G. The use of bacteriophages in biotechnology and recent insights into proteomics. Antibiotics 2022, 11, 653. [Google Scholar] [CrossRef] [PubMed]
- Lin, J.; Du, F.; Long, M.; Li, P. Limitations of phage therapy and corresponding optimization strategies: A review. Molecules 2022, 27, 1857. [Google Scholar] [CrossRef] [PubMed]
- Alghamdi, F.; Shakir, M. The influence of Enterococcus faecalis as a dental root canal pathogen on endodontic treatment: A systematic review. Cureus 2020, 12, e7257. [Google Scholar] [CrossRef] [PubMed]
- Lee, D.; Im, J.; Na, H.; Ryu, S.; Yun, C.-H.; Han, S.H. The novel Enterococcus phage vB_EfaS_HEf13 has broad lytic activity against clinical isolates of Enterococcus faecalis. Front. Microbiol. 2019, 10, 2877. [Google Scholar] [CrossRef]
- Shlezinger, M.; Khalifa, L.; Houri-Haddad, Y.; Coppenhagen-Glazer, S.; Resch, G.; Que, Y.-A.; Beyth, S.; Dorfman, E.; Hazan, R.; Beyth, N. Phage therapy: A new horizon in the antibacterial treatment of oral pathogens. Curr. Top. Med. Chem. 2017, 17, 1199–1211. [Google Scholar] [CrossRef] [PubMed]
- Figueiredo, C.M.; Malvezzi Karwowski, M.S.; da Silva Ramos, R.C.P.; de Oliveira, N.S.; Peña, L.C.; Carneiro, E.; Freitas de Macedo, R.E.; Rosa, E.A.R. Bacteriophages as tools for biofilm biocontrol in different fields. Biofouling 2021, 37, 689–709. [Google Scholar] [CrossRef] [PubMed]
- Maat, V.D. Adaptations of Hospital-Acquired Enterococcus Faecium. Ph.D. Thesis, Utrecht University, Utrecht, The Netherlands, 2022. [Google Scholar]
- Fernández, L.; Duarte, A.C.; Rodríguez, A.; García, P. The relationship between the phageome and human health: Are bacteriophages beneficial or harmful microbes? Benef. Microbes 2021, 12, 107–120. [Google Scholar] [CrossRef] [PubMed]

| Primer | Sequence (5-3) | Length | Tm | GC% | Strand |
|---|---|---|---|---|---|
| Forward primer 6 | CCATGTGCTGAACGCCTTTT | 20 | 59.6 | 50 | Plus |
| Reverse primer 6 | CTGTGGCGATTGAGCGTTTC | 20 | 60.1 | 55 | Minus |
| Forward primer 9 | AGCTGACTCTTCGCTTGGAG | 20 | 59.7 | 55 | Plus |
| Reverse primer 9 | AAAAGGCGTTCAGCACATGG | 20 | 59.6 | 50 | Minus |
| Code Test | EF.1 | EF.2 | EF.3 | EF.4 | EF.5 |
|---|---|---|---|---|---|
| Motility | ─ | ─ | ─ | ─ | ─ |
| Catalase | ─ | ─ | ─ | ─ | ─ |
| Oxidase | ─ | ─ | ─ | ─ | ─ |
| Glucose fermentation | + | + | + | + | + |
| Nitrate Reduction | + | + | + | + | + |
| Vogues Proskour | + | + | + | + | + |
| Indole Production | ─ | ─ | ─ | ─ | ─ |
| Citrate Utilization | ─ | ─ | ─ | ─ | ─ |
| H2S Production | ─ | ─ | ─ | ─ | ─ |
| Urease | ─ | ─ | ─ | ─ | ─ |
| Coagulase | ─ | ─ | ─ | ─ | ─ |
| Test Group | Antimicrobial Agent | Dose | E. faecalis Isolates | ||||
|---|---|---|---|---|---|---|---|
| EF.1 | EF.2 | EF.3 | EF.4 | EF.5 | |||
| Glycopeptides | Vancomycin | 30 µg | R | R | R | R | R |
| Monobactam | Aztreonam | 30 µg | R | R | R | R | R |
| Cyclic polypeptide | Bacitracin | 0.04 µg | R | R | R | R | R |
| Lincomycin | Clindamycin | 2 µg | R | R | R | R | R |
| Fusidane | Fusidic acid | 10 µg | S | S | S | S | S |
| Carbapenem | Imipenem | 10 µg | R | S | S | S | S |
| Quinolone | Nalidixic acid | 30 µg | R | R | R | R | R |
| Fluoroquinolone | Norfloxacin | 10 µg | R | R | I | R | I |
| Ofloxacin | 5 µg | I | S | S | S | S | |
| Aminoglycoside | Streptomycin | 10 µg | R | R | R | R | I |
| No | mobileOG ID | ORF Start | End | Length | Strand | GC% | P_ident | e-Value | Gene Name | Major mobileOG Category |
|---|---|---|---|---|---|---|---|---|---|---|
| 0 | MobileOG_000028221 | 6152 | 8503 | 784 | −1 | 0.409 | 99.4 | 0 | gp59 | Replication/Recombination |
| 1 | MobileOG_000381065 | 12,559 | 12,993 | 145 | −1 | 0.423 | 98.6 | 4.80 × 10−74 | gp48 | Phage |
| 2 | MobileOG_000385144 | 14,480 | 14,920 | 147 | −1 | 0.363 | 98.6 | 5.9 × 10−80 | efb37 | Replication/Recombination |
| 3 | MobileOG_000766253 | 15,455 | 16,207 | 251 | −1 | 0.335 | 99.6 | 1.70 × 10−143 | NA:Keyword | Stability/Transfer/Defense |
| 4 | MobileOG_000766252 | 16,220 | 17,584 | 455 | −1 | 0.415 | 100 | 1.60 × 10−256 | NA:Keyword | Replication/Recombination |
| 5 | MobileOG_000762900 | 17,596 | 18,372 | 259 | −1 | 0.405 | 100 | 6.80 × 10−148 | NA:Keyword | Replication/Recombination |
| 6 | MobileOG_000028219 | 25,673 | 26,386 | 238 | −1 | 0.445 | 99.6 | 3.90 × 10−142 | gp22 | Phage/Lysis/Lysogeny |
| 7 | MobileOG_000028218 | 26,734 | 29,760 | 1009 | −1 | 0.403 | 96.7 | 0 | gp20 | Stability/Transfer/Defense |
| 8 | MobileOG_000773315 | 29,773 | 33,765 | 1331 | −1 | 0.421 | 99.5 | 0 | NA:Keyword | Phage |
| 9 | MobileOG_000028217 | 33,779 | 36,664 | 962 | −1 | 0.45 | 98.8 | 0 | gp17 | Phage/Structural |
| 10 | MobileOG_000762915 | 37,496 | 38,185 | 230 | −1 | 0.439 | 100 | 9.10 × 10−128 | NA:Keyword | Phage |
| 11 | MobileOG_000763662 | 38,206 | 38,640 | 145 | −1 | 0.411 | 99.3 | 1.40 × 10−78 | NA:Keyword | Phage |
| 12 | MobileOG_000762916 | 39,411 | 39,815 | 135 | −1 | 0.44 | 97.8 | 7.80 × 10−71 | NA:Keyword | Phage |
| 13 | MobileOG_000766248 | 39,875 | 40,315 | 147 | −1 | 0.44 | 98.6 | 7.20 × 10−70 | NA:Keyword | Phage |
| 14 | MobileOG_000763661 | 40,470 | 41,276 | 269 | −1 | 0.408 | 98.9 | 4.30 × 10−145 | NA:Keyword | Phage |
| 15 | MobileOG_000773312 | 42,110 | 42,865 | 252 | −1 | 0.43 | 99.6 | 1.50 × 10−138 | NA:Keyword | Phage |
| 16 | MobileOG_000381009 | 42,877 | 44,412 | 512 | −1 | 0.411 | 99.8 | 4.10 × 10−290 | gp5 | Phage/Structural |
| 17 | MobileOG_000766245 | 44,469 | 45,740 | 424 | −1 | 0.424 | 100 | 8.30 × 10−252 | NA:Keyword | Phage |
| 18 | MobileOG_000768258 | 46,428 | 47,027 | 200 | −1 | 0.397 | 91 | 2.10 × 10−96 | NA:Keyword | Phage |
| Bacterial Species | E. faecalis_phage-01 | E. faecalis_phage-02 |
|---|---|---|
| E. faecalis | + | + |
| S. mutans | − | − |
| E. faecium | − | − |
| S. aureus | − | − |
| E. coli | − | − |
| P. aeruginosa | − | − |
| ID | µg/mL | O.D | Mean O.D | ±SE | Viability % | Toxicity % | IC50 ± SD | ||
|---|---|---|---|---|---|---|---|---|---|
| OEC | -------- | 0.622 | 0.625 | 0.619 | 0.622 | 0.001732 | 100 | 0 | µg |
| E. faecalis_phage-01 | 1000 | 0.032 | 0.038 | 0.033 | 0.034333 | 0.001856 | 5.51982851 | 94.48017149 | 563.46 ± 4.93 |
| 500 | 0.317 | 0.287 | 0.302 | 0.302 | 0.00866 | 48.55305466 | 51.44694534 | ||
| 250 | 0.547 | 0.557 | 0.562 | 0.555333 | 0.00441 | 89.28188639 | 10.71811361 | ||
| 125 | 0.62 | 0.617 | 0.617 | 0.618 | 0.001 | 99.35691318 | 0.643086817 | ||
| 62.5 | 0.609 | 0.621 | 0.611 | 0.613667 | 0.003712 | 98.6602358 | 1.339764202 | ||
| 31.25 | 0.608 | 0.624 | 0.619 | 0.617 | 0.004726 | 99.19614148 | 0.803858521 | ||
| E. faecalis_phage-02 | 1000 | 0.081 | 0.108 | 0.093 | 0.094 | 0.00781 | 15.11254019 | 84.88745981 | 700 ± 8.59 |
| 500 | 0.46 | 0.473 | 0.469 | 0.467333 | 0.003844 | 75.13397642 | 24.86602358 | ||
| 250 | 0.622 | 0.617 | 0.619 | 0.619333 | 0.001453 | 99.57127546 | 0.428724544 | ||
| 125 | 0.608 | 0.624 | 0.62 | 0.617333 | 0.004807 | 99.24973205 | 0.750267953 | ||
| 62.5 | 0.619 | 0.623 | 0.621 | 0.621 | 0.001155 | 99.8392283 | 0.160771704 | ||
| 31.25 | 0.625 | 0.62 | 0.621 | 0.622 | 0.001528 | 100 | 0 | ||
Disclaimer/Publisher’s Note: The statements, opinions and data contained in all publications are solely those of the individual author(s) and contributor(s) and not of MDPI and/or the editor(s). MDPI and/or the editor(s) disclaim responsibility for any injury to people or property resulting from any ideas, methods, instructions or products referred to in the content. |
© 2024 by the authors. Licensee MDPI, Basel, Switzerland. This article is an open access article distributed under the terms and conditions of the Creative Commons Attribution (CC BY) license (https://creativecommons.org/licenses/by/4.0/).
Share and Cite
Ramadan, A.; Abdel-Monem, M.O.; El-Dougdoug, N.K.; Mekky, A.E.; Elaskary, S.A.; Al-Askar, A.A.; Metwally, S.A.; El-Sayed, A.F.; AbdElgayed, G.; Saied, E.; et al. Fully Characterized Effective Bacteriophages Specific against Antibiotic-Resistant Enterococcus faecalis, the Causative Agent of Dental Abscess. Medicina 2024, 60, 501. https://doi.org/10.3390/medicina60030501
Ramadan A, Abdel-Monem MO, El-Dougdoug NK, Mekky AE, Elaskary SA, Al-Askar AA, Metwally SA, El-Sayed AF, AbdElgayed G, Saied E, et al. Fully Characterized Effective Bacteriophages Specific against Antibiotic-Resistant Enterococcus faecalis, the Causative Agent of Dental Abscess. Medicina. 2024; 60(3):501. https://doi.org/10.3390/medicina60030501
Chicago/Turabian StyleRamadan, Asmaa, Mohamed O. Abdel-Monem, Noha K. El-Dougdoug, Alsayed E. Mekky, Shymaa A. Elaskary, Abdulaziz A. Al-Askar, Shimaa A Metwally, Ahmed F. El-Sayed, Gehad AbdElgayed, Ebrahim Saied, and et al. 2024. "Fully Characterized Effective Bacteriophages Specific against Antibiotic-Resistant Enterococcus faecalis, the Causative Agent of Dental Abscess" Medicina 60, no. 3: 501. https://doi.org/10.3390/medicina60030501
APA StyleRamadan, A., Abdel-Monem, M. O., El-Dougdoug, N. K., Mekky, A. E., Elaskary, S. A., Al-Askar, A. A., Metwally, S. A., El-Sayed, A. F., AbdElgayed, G., Saied, E., & Khedr, M. (2024). Fully Characterized Effective Bacteriophages Specific against Antibiotic-Resistant Enterococcus faecalis, the Causative Agent of Dental Abscess. Medicina, 60(3), 501. https://doi.org/10.3390/medicina60030501

